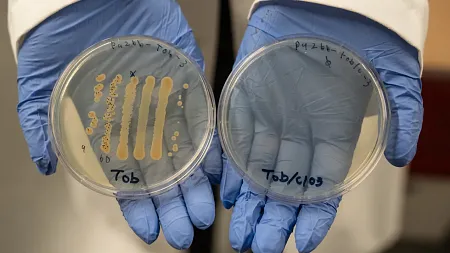

Experiential Learning | Research & Innovation | Community Impact | Career Preparation | Teaching Excellence | 21st Century Liberal Arts | Building Community | Good Vibes | CAS Spotlights | All Stories | Past Issues
Research & Innovation
 
   
   
   
   
   
   
   
   
   
   
   
   
   
   
   
   
   
   
   
   
   
   
   
  Experiential Learning | Research & Innovation | Community Impact | Career Preparation | Teaching Excellence | 21st Century Liberal Arts | Building Community | Good Vibes | CAS Spotlights | All Stories | Past Issues